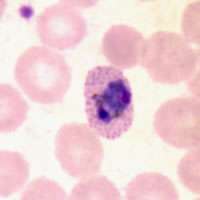

Schüffner's dots
Trophozoites of P. ovale in thin blood smears. Schüffner's dots can be seen.
Schüffner's dots refers to a hematological finding that is associated with malaria,[1] exclusively found in Plasmodium ovale and Plasmodium vivax.[2]
Plasmodium vivax induces morphologic alterations in infected host erythrocytes that are visible by light microscopy in Romanovsky-stained blood smears as multiple brick-red dots. These morphologic changes, referred to as Schüffner's dots, are important in the identification of this species of malarial parasite and have been associated by electron microscopy with caveolavesicle complexes along the erythrocyte plasmalemma.[3]
They are named for Wilhelm Schüffner, who described them in 1904.[4]
References
External links
- http://pathmicro.med.sc.edu/parasitology/blood-proto.htm
- http://www.wadsworth.org/parasitology/critiquesJun05.htm
This article is issued from Wikipedia - version of the 3/23/2014. The text is available under the Creative Commons Attribution/Share Alike but additional terms may apply for the media files.